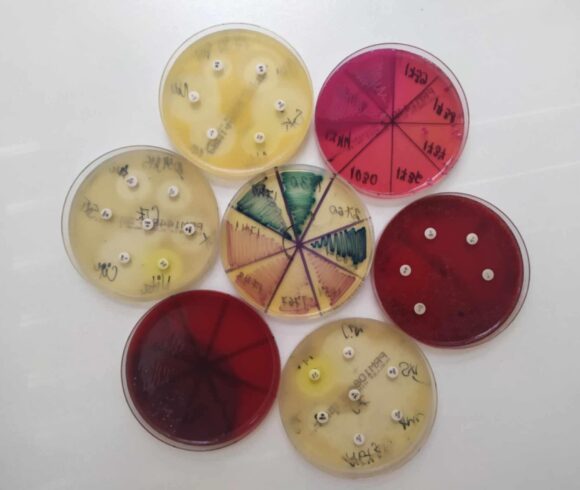

Ученици от НПГ посетиха микробиологичната лаборатория към МБАЛ „Иван Скендеров“, гр. Гоце Делчев
Учениците от 8в клас, под ръководството на старши учител Елена Ташкова, посетиха микробиологичната лаборатория към МБАЛ „Иван Скендеров“, гр. Гоце Делчев.
Поводът бе отбелязването на 80 години от смъртта на Стамен Григоров (27.10.1945 г. )- български лекар и микробиолог, открил млечнокиселата бактерия, която стои в основата на производството на традиционното българско кисело мляко.
В лабораторията учениците се запознаха с ежедневната работа на микробиолозите. Станаха свидетели как се правят различни изследвания – анализ на проби за наличие на бактерии, гъбички и вируси, както и диагностика на инфекциозни заболявания. Доктор Тренева демонстрира пред учениците приготвянето на хранителни среди, как се посяват и култивират микроорганизми и как чрез микроскопски наблюдения се определя техният вид и форма.
Посещението завърши с разговор за ползите от съвременната микробиология в лечението на различни заболявания.
Благодарим на доктор Тренева за гостоприемството и полезната и любопитна информация, която учениците получиха извън класната стая!